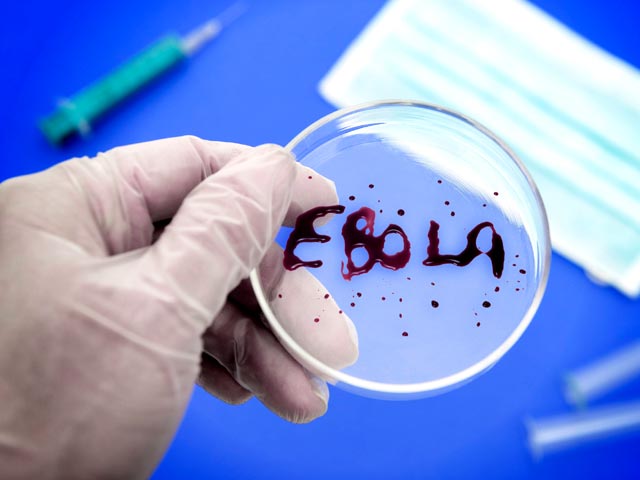

В Либерии введено чрезвычайное положение и объявлен национальный пост из-за лихорадки Эбола
Президент Либерии Элен Джонсон-Серлиф объявила о введении в стране режима чрезвычайного положения в связи с продолжающимся распространением лихорадки Эбола. Он будет действовать 90 дней. Одновременно лидер страны обратилась к гражданам с просьбой усиленно поститься и молиться об избавлении от страшной болезни. Религиозные лидеры говорят, что знают, кто во всем виноват.
"Правительство и народ Либерии добиваются чрезвычайных мер для обеспечения выживания нашей страны и защиты жизни граждан. Я объявляю режим чрезвычайного положения на всей территории республики, который вступает в силу с 6 августа 2014 года и будет действовать в течение 90 дней", - цитирует сообщение президента Reuters.
Ранее Либерия закрыла почти все пограничные пункты пропуска и школы, чтобы предотвратить распространение лихорадки. В соседней Сьерра-Леоне режим ЧП действует с 31 июля. Общее количество заболевших в странах Западной Африки превысило 1,7 тысячи человек, более 930 погибли.
The Washington Post цитирует африканские СМИ, которые сообщают о том, что президент Джонсон-Серлиф во вторник, 5 августа, попросила жителей Либерии поститься в течение трех дней и молиться о прощении грехов. "Я призываю всех либерийцев соблюдать три дня национального поста и в молитве искать лица Божьего, чтобы он помиловал нас и простил нам наши грехи, исцелил нашу землю, потому что мы продолжаем бороться против смертельного вируса Эбола", - сказала политик.
Издание рассказывает о том, что религиозные лидеры либерийского Совета церквей нашли предполагаемых виновников эпидемии. В заявлении от имени Совета говорится о том, что вспышка инфекции может быть объяснена с точки зрения библейских пророчеств. "Эбола - это чума. Либерийцы должны молиться и искать Божьего прощения за коррупцию и аморальность, например гомосексуализм, которые продолжают проникать в наше общество. Как христиане, мы должны покаяться и искать Божьего прощения", - говорится в заявлении.
The Washington Post рассказывает о том, что в Либерии уже начали появляться группы вооруженных людей, которые пытаются убивать "во имя Эбола". В то же время местное население не доверяет западной медицине, а местные власти не всегда успевают оперативно и с соблюдением должных мер безопасности хоронить умерших. В охваченных вспышкой заболевания странах развернута просветительско-пропагандистская кампания, призывающая жителей обращаться к медикам при первых признаках заболевания. В Сьерра-Леоне к выявлению больных также подключены силы правопорядка.
Во вторник, 7 августа, передает AP, в США был эвакуирован второй американский миссионер, заразившийся лихорадкой Эбола. Его коллега в минувшие выходные был доставлен в инфекционное отделение больницы Университета Эмори в Атланте и начал экспериментальное лечение. По некоторым данным, лекарство, которое ранее не тестировалась на людях, дало положительные результаты - у больного упала температура, а сыпь стала значительно меньше.
Доктор Кент Бранти и Нэнси Уацьюлд работали в одной команде, представляя в Африке Церковь евангелистов. Они заразились, когда ухаживали за больными Эбола в больнице неподалеку от Монровии. В настоящее время в Либерии продолжают работать медики и гигиенисты из волонтерских и благотворительных организаций, в том числе американские "Добрые самаряне".
The Guardian сообщает, что авиакомпания British Airways приостановила рейсы в Либерию и Сьерра-Леоне минимум до конца августа. Самолеты британской компании летали в Западную Африку четыре раза в неделю. Теперь пассажирам предложено вернуть деньги за билеты и перебронировать полеты на более поздние даты.
Издание напоминает о том, что в Нигерии были также выявлены заболевшие лихорадкой Эбола. Заражение произошло во время поездок в Либерию и Гвинею. BBC указывает на то, что Нигерия является самой густонаселенной страной региона. Вторая зарегистрированная в Нигерии смерть от Эбола вызывает серьезные опасения. Нигерийские власти подняли вопрос о введении временного моратория на авиаперевозки.
Всемирная организация здравоохранения отложила до следующей недели совещание по вопросам медицинской этики, на котором должен решиться вопрос о допустимости экспериментального лечения от Эбола. Некоторые специалисты по инфекционным заболеваниям призывают к широкому применению не прошедших апробацию средств, в то время как другие говорят о составлении подробных планов по выявлению и изоляции больных.
Напомним, в настоящее время вакцин и лекарств от лихорадки Эбола не существует. Смертность от этого заболевания составляет около 90%, однако при раннем обращении шансы пациентов на выживание повышаются. Среди заболевших в Западной Африке смертность удерживается на уровне 55%.
Симптомы Эбола включают в себя высокую температуру, кровотечения и поражение центральной нервной системы. Инкубационный период составляет от двух до 21 дня. Переносчиками инфекции считаются животные из семейства крылановых, в первую очередь фруктовые летучие мыши (крыланы). После выявления вспышки лихорадки Эбола в Западной Гвинее был введен запрет на употребление этих животных в пищу.